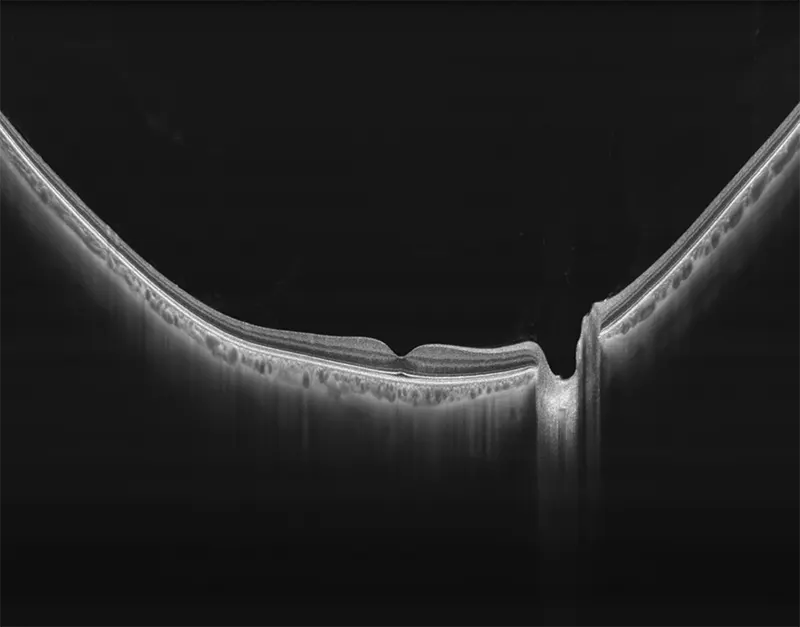

TowardPI BMizar 400KHz Full-Range SS-OCT
Características principales del TowardPI BMizar 400KHz Full-Range SS-OCT:
- Módulo de Angiografía Anterior y Posterior con IA
- Análisis digital de 1,4 μm y óptico de 3,8 μm
- Velocidad de seguimiento ocular de 128 Hz
- Rango completo de campo amplio de 24 mm
- Diseño óptico excepcional
- Angiografía OCT alcanza un nivel sin precedentes.
- OCTA de 24 mm de ancho en 15 segundos
- Amplio rango adaptativo dióptrico
Descripción general del TowardPI BMizar 400KHz Full-Range SS-OCT
BMizar (BM-400K) es el OCT más potente de la industria con una fuente de barrido de 400 kHz. Su excepcional diseño óptico eleva la experiencia de la Angiografía OCT a un nivel sin precedentes. Con imágenes de alta definición de la retina, la coroides y el segmento anterior, cubre sin esfuerzo un área increíblemente grande en un solo escaneo (logrando un OCTA de 24 mm de ancho en solo 7-15 segundos).
Esta tecnología revolucionaria es un cambio de juego para las prácticas clínicas, particularmente en el diagnóstico y tratamiento de enfermedades como DR, RVO, RAO y más. Además, el BMizar ofrece un amplio rango de adaptación dióptrica, lo que hace factible realizar todo tipo de escaneos OCT/OCTA en pequeños animales como conejos, cobayas e incluso ratones sin necesidad de lentes adicionales. Es verdaderamente un equipo de ensueño para cualquier usuario de OCT.
Galería OCTs del TowardPi BMizar
| Velocidad de escaneo A | 400.000/s |
|---|---|
| Resolución axial | 3,8 micras (óptica) |
| Resolución lateral | 10 micras (óptica) |
| Rango dióptrico | -30 D a +30 D |
| Campo de visión | 120° |
| Longitud de escaneo de la línea anterior | 3-16 mm, ajustable |
| Profundidad de escaneo posterior | 3 mm, 6 mm |
| Profundidad de escaneo anterior | 6 mm |
| Patrón OCTA (retina) | 3 x 3 mm a 12 x 12 mm, ajustable, 24 x 20 mm |
| Patrón OCTA (anterior) | 6 x 6 mm, 16 x 12 mm, ajustable |
| Posiciones de la línea OCTA | 512-1280 |
| Número máximo de escaneos A en escaneos B | 1536 |
| Patrón máximo de escaneo OCTA | 24 x 20 mm (captura única) |
| Tiempo típico de adquisición OCTA | 1,8 s (3-6 mm) 7,2 s (12 mm), 15 s (24 mm) |